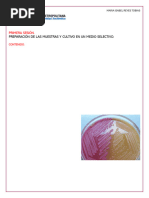

1.
Práctica 1
1.1. Objetivos
Desarrollar las habilidades experimentales concernientes al área de microbiologı́a, que le permitirán al alumno
desarrollar las prácticas posteriores con éxito.
1.2. Contenido
1. Cinética microbiana.
2. Preparación de soluciones y medios de cultivo.
3. Técnicas asépticas de siembra.
1.3. Cinética microbiana
1.3.1. Materiales y Equipos
Materiales y Reactivos
Piseta con etanol 70 %.
Piseta con agua destilada.
Mechero bunsen.
Matraz erlenmeyer con E. coli cultivada ”overnight”.
Matraz Erlenmeyer con 50 mL de medio LB lı́quido y estéril.
Caja con puntas para micropipeta estériles de 1000 µL.
10 microtubos para centrı́fuga estériles.
Celda de plástico para espectrofotómetro.
Micropipeta de 1000 µL.
Equipos
Incubadora con agitación orbital.
Espectrofotómetro de luz visible.
1.3.2. Desarrollo Experimental
1. Reitrar el matraz Erlenmeyer con medio LB lı́quido y estéril de la incubadora orbital.
2. En el espacio de trabajo, conectar la manguera del mechero bunsen a la toma de gas y prender el mechero
usando un encendedor de mano.
3. Usando la piseta con etanol al 70 %, desinfectar la superficie de trabajo dentro de la campana de esterilidad
(ver Fig. 1.1). Tener cuidado dado que el etanol es flamable.
7
�Figura 1.1: Campana de esterilidad provocada por un menchero bunsen. En el gráfico, está representada por el área
dentro del cı́rculo rojo.
Figura 1.2: Orden de los elementos dentro del espacio de trabajo. Se debe trabajar siempre de ”más limpio”(lado
izquierdo) a ”más sucio”(lado derecho). En caso que el usuario sea zurdo, invertir el flujo de trabajo.
4. Usando la piseta con etanol al 70 %, desinfectar los materiales de trabajo (micropipeta, caja de puntas y
matraz; ver Fig. 1.2) y ponerlos dentro de la campana de esterilidad. Tener cuidado dado que el etanol es
flamable.
5. Con ayuda de la micropipeta (ver Fig. 1.3), tomar una punta estéril de la caja de puntas.
Figura 1.3: Micropipeta Eppendorf Research plus monocanal [epp, 2016].
6. Usando la micropipeta, tomar 1 mL del matraz erlenmeyer con medio LB lı́quido y estéril, y depositarlo
en uno de los microtubos estériles. Descartar la punta contaminada.
7. Vertir el contenido del microtubo de centrı́fuga en la celda para espectrofotómetro.
8. Con ayuda del espectrofotómetro, medir la OD600 de la muestra tomada antes de la inoculación.
9. Retirar el matraz Erlenmeyer con el cultivo ”overnight”de la incubadora orbital.
8
�10. Con ayuda de la piseta con etanol 70 %, desinfectar el matraz y colocarlo dentro del área de trabajo.
11. Con ayuda de la micropipeta, tomar una punta estéril de la caja de puntas.
12. Usando la micropipeta, tomar 1 mL del matraz erlenmeyer con E. coli y transferirlo al matraz con medio
limpio y estéril. Descartar la punta contaminada.
13. Mezclar suavemente el matraz recién inoculado.
14. Usando la micropipeta y una punta estéril nueva, tomar 1 mL de muestra del matraz inoculado y colocarlo
en un microtubo para centrı́fuga estéril.
15. Regresar el matraz erlenmeyer a la incubadora de agitación orbital e incubar @ 200 RPM; T= 37 C.
16. Vertir el contenido del microtubo de centrı́fuga en la celda para espectrofotómetro.
17. Con ayuda del espectrofotómetro, medir la OD600 de la muestra tomada.
18. Repetir los últimos 5 pasos cada t= 30 min.
19. Registrar los resultados en la Tabla 1.1 y usando la Figura 1.4.
OD600nm Blanco
t (h) OD600nm OD600nm -Bco
0.0
0.5
1.0
1.5
2.0
2.5
3.0
3.5
Tabla 1.1: Registro de OD600nm del cultivo de E. coli.
Figura 1.4: Representación gráfica de la cinética microbiana.
9
�1.4. Preparación de soluciones y medios de cultivo
1.4.1. Materiales y Equipos
Materiales y Reactivos
Piseta con etanol 70 %.
Piseta con agua destilada.
Agua GBM.
100 mL TAE 10X.
Mechero bunsen.
1 Frasco Schott 1 L.
1 tubo cónico para centrı́fuga de 15 mL.
2 Matraces erlenmeyer de 250 mL.
1 probeta 100 mL.
1 probeta 1 L.
4 charolas para pesar.
2 espátulas.
6 cajas Petri desechables.
Agar Nutritivo
Extracto de Levadura.
Triptona.
NaCl.
Papel aluminio.
Algodón.
Gasa.
Papel estraza.
Equipos
Incubadora con control de temperatura.
Balanza analı́tica.
Autoclave.
1.4.2. Desarrollo Experimental
Bu↵er TAE 1X
1. Hacer los cálculos para preparar 1 L de Bu↵er TAE 1X.
TAE 10X a utilizar: .
Agua GBM a utilizar: .
2. Medir la cantidad de TAE 10X necesario y vertirlo en el frasco Schott.
3. Medir la cantidad de Agua GBM necesaria y vertirla en el frasco Schott.
4. Etiquetar el frasco y colocar en refrigeración @ T= 4 C.
10
� Reactivo Cantidad Cantidad a Pesar
Extracto de Levadura 5g
Triptona 10 g
NaCl 10 g
dH2 O aforar a 1 L aforar a 50 mL
Tabla 1.2: Composición del medio LB lı́quido.
Agar Nutritivo y Medio LB
1. Hacer los cálculos necesarios para preparar 50 mL de medio LB lı́quido. Utilizar la Tabla 1.2 como
referencia.
2. Utilizando las charolas, espátulas y la balanza analı́tica, pesar las cantidades calculadas en el paso anterior.
Es importante no ocupar la misma espátula para distintos reactivos.
3. Usando la probeta, medir 50 mL de agua destilada.
4. Vertir la mitad del agua destilada en el matraz erlenmeyer de 250 mL.
5. Posteriormente, vertir cada uno de los componentes y agitar hasta lograr la disolución. No iniciar a vertir
el siguiente componente hasta no disolver el primero.
6. Hacer un tapón de algodón y gasa y colocarlo en el matraz. Posteriormente, colocar un capuchón de papel
estraza y etiquetar el matraz.
7. Hacer los cálculos necesarios para preparar 130 mL de medio Agar Nutritivo.
8. Utilizando la charola, espátula y la balanza analı́tica, pesar la cantidad calculada en el paso anterior.
Agar Nutritivo a utilizar: .
9. Usando la probeta, medir 130 mL de agua destilada.
10. Vertir la mitad del agua destilada en el matraz erlenmeyer de 250 mL.
11. Vertir el agar nutritivo y agitar hasta lograr la disolución.
12. Hacer un tapón con papel aluminio y etiquetar el matraz..
13. Utilizando el mechero bunsen, llevar la mezcla a ebullición. Tener cuidado para no provocar explosiones o
derrames del lı́quido.
14. Una vez listos los matraces, meter en el autoclave.
15. Cerrar el autoclave y permitir que purgue el exceso de aire.
16. Esterilizar por calor húmedo @ T= 121 C; P= 15 psi; t= 15 min.
17. Desconectar el autoclave y dejar enfriar.
18. Retirar los matraces del autoclave.
19. En el espacio de trabajo, conectar la manguera del mechero bunsen a la toma de gas y prender el mechero
usando un encendedor de mano.
20. Usando la piseta con etanol al 70 %, desinfectar la superficie de trabajo dentro de la campana de esterilidad
(ver Fig. 1.1). Tener cuidado dado que el etanol es flamable.
21. Usando la piseta con etanol al 70 %, desinfectar el matraz y las cajas Petri y colocarlas dentro del espacio
de trabajo.
22. Vertir 20 mL de medio en cada caja. Se debe ser cuidadoso, pues movimientos brucos pueden generar
contaminación (ver la Fig. 1.5 como referencia).
23. Una vez que el medio ha solidificado, tapar las cajas, etiquetarlas y ponerlas en prueba de esterilidad,
junto con el matraz erlenmeyer con Medio LB @ T= 37 C; t= 24h.
24. Revisar el material para corroborar que no haya contaminación.
11
�Figura 1.5: Esquema para el vertido del Agar en las cajas Petri. Toda la manipulación se debe hacer dentro del área
estéril. Las cajas, una vez con medio, deben de permanecer dentro de la campana de esterilidad con la tapa abierta. No
pasar encima de las cajas una vez que tienen medio.
1.5. Técnicas asépticas de siembra
1.5.1. Materiales y Equipos
Materiales y Reactivos
Piseta con etanol 70 %.
Piseta con agua destilada.
Mechero bunsen.
Vaso de pp 600 mL con etanol 96 %.
1 varilla de extensión.
1 caja de puntas estériles de 1000 mL.
1 asa de siembra
9 cajas Petri con Agar Nutritivo.
Caja Petri con muestra de E. coli.
Matraz erlenmeyer con E. coli cultivada ”overnight”.
Equipos
Incubadora con control de temperatura.
1.5.2. Desarrollo Experimental
Siembra de muestra lı́quida
1. En el espacio de trabajo, conectar la manguera del mechero bunsen a la toma de gas y prender el mechero
usando un encendedor de mano.
2. Usando la piseta con etanol al 70 %, desinfectar la superficie de trabajo dentro de la campana de esterilidad
(ver Fig. 1.1). Tener cuidado dado que el etanol es flamable.
3. Usando la piseta con etanol al 70 %, desinfectar los materiales de trabajo (micropipeta, caja de puntas,
caja Petri, vaso de precipitados y matraz; ver Fig. 1.6) y ponerlos dentro de la campana de esterilidad.
Tener cuidado dado que el etanol es flamable.
4. Usando la micropipeta, tomar 0.1 mL del matraz erlenmeyer con E. coli, y depositarlo en una caja Petri
(ver Fig. 1.7).
5. Sacar la varilla del vaso de precipitados con etanol al 96 % y flamearla en el mechero. Esperar a que enfrı́e
en el aire.
12
� Figura 1.6: Orden de los elementos dentro del espacio de trabajo para la técnica de extensión por varilla.
Figura 1.7: Representación gráfica de la técnica de extensión por varilla [Brock et al., 2003].
6. Usando la varilla, extender la muestra por toda la caja Petri (ver Fig. 1.7).
7. Sumergir la varilla en etanol al 96 % y volverla a flamear. Una vez frı́a, regresar al vaso de precipitados.
8. Etiquetar la caja e incubar @ T= 37 C; t= 24 h.
Siembra de muestra sólida
1. En el espacio de trabajo, conectar la manguera del mechero bunsen a la toma de gas y prender el mechero
usando un encendedor de mano.
2. Usando la piseta con etanol al 70 %, desinfectar los materiales de trabajo (asa de siembra y cajas Petri;
ver Fig. 1.8) y ponerlos dentro de la campana de esterilidad. Tener cuidado dado que el etanol es flamable.
Figura 1.8: Orden de los elementos dentro del espacio de trabajo para la técnica de estrı́a y estrı́a cruzada.
3. Tomar el asa de siembra y flamearla con el mechero para esterilizarla.
4. Esperar a que el asa enfrı́e en el aire.
5. Con ayuda del asa, tomar una colonia de la caja previamente inoculada.
6. Transferir la colonia a la caja estéril y sembrarla por estrı́a simple (ver Fig. 1.9).
7. Esterilizar nuevamente el asa usando el mechero.
8. Tomar el asa de siembra y flamearla con el mechero para esterilizarla.
13
� Figura 1.9: Técnica de sembrado por estrı́a simple.
9. Esperar a que el asa enfrı́e en el aire.
10. Con ayuda del asa, tomar una colonia de la caja previamente inoculada.
11. Transferir la colonia a la caja estéril y sembrarla por estrı́a cruzada (ver Fig. 1.10).
12. Esterilizar nuevamente el asa usando el mechero.
Figura 1.10: Técnica de sembrado por estrı́a cruzada. Primero se realiza el paso 1, luego el 2 y ası́ sucesivamente hasta
el 4. Esterilizar el asa de siembra entre cada estrı́a.
13. Etiquetar ambas caja es incubarlas @ T= 37 C; t= 24 h.
14. Pasado este tiempo, revisar las cajas para asegurarse que el crecimiento sea correcto y no exista ninguna
contaminación.
14